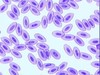
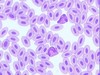
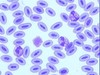
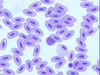
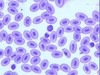

Hematology Exam- Avian Flashcards
(16 cards)
For blood draw, what is the first thing you do?
Weigh the bird
How do you know how much blood to remove?
Depends on the body size and health status
What veins are commonly used for blood draw on avian?
Jugular- with a 22-25 g needle and 3-6cc syringe
Cutaneous ulnar (Within the wing)- 25 g needle no syringe
Medial Metatarasal (Leg)- 25 G no syringe
What increases with age in avian?
PCV
What does an RBC look like in Avain?
Oval and nucleated
What are the granulocytes in Avain?
Heterophil, Eosinophil, and basophils
What does a Heterophil look like?
Colorless cytoplasm
Contains pink granules
Which Species is this?
and what cells are these?
Avian
RBC
Which wbc is this?
Heterophil
Which WBC is this?
Heterophil
Which wbc is this?

Eosinophil
What does an Eosinophil look like in birds?
Same size as Heterophils
Round, pink granules
Granules stain more intensely than the heterophils
What does a Basophil look like?
Non lobed nucleus
many granules
Which WBC is this?
Basophil
What do platelets look like in birds?
Nucleated
may contain one or more eosinophilic granule
What is this?
platelets